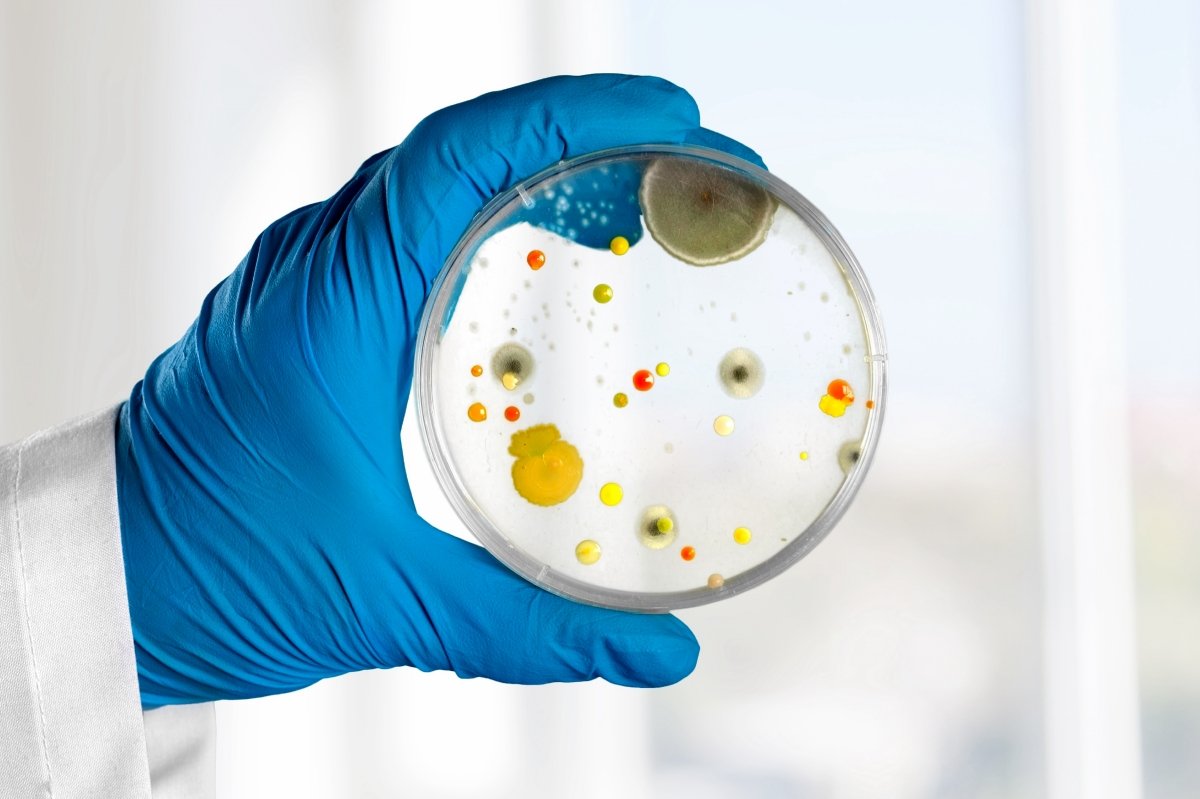

R&D Talk นักวิจัยขอเล่าเรื่อง EP.21 การทดสอบผลิตภัณฑ์เครื่องสำอาง ตอน การทดสอบทางชีวภาพ (Microbial test)

การทดสอบทางชีวภาพในผลิตภัณฑ์เครื่องสำอางเพื่อคงสภาพเนื้อผลิตภัณฑ์ให้อยู่ได้นานตามวันหมดอายุ ผลิตภัณฑ์ส่วนใหญ่จึงมีสารต้านเชื้อจุลินทรีย์ เพื่อให้ฆ่าเชื้อแบคทีเรีย ยีสต์ และรา หรือยับยั้งการเจริญเติบโตของจุลินทรีย์ระหว่างเปิดใช้ผลิตภัณฑ์ ความคงสภาพทางชีวภาพจึงเป็นเรื่องสำคัญ เพราะตำรับเครื่องสำอางต้องไม่มีเชื้อจุลินทรีย์เกิดขึ้น และต้องเป็นไปตามมาตรฐานที่กำหนด ใน EP. นี้ จะพูดถึงวิธีการทดสอบทางจุลชีววิทยา เชื้อจุลินทรีย์ และสารกันเสียที่ใช้ในเครื่องสำอาง


International Organization for Standardization (ISO)
มาตรฐาน ISO ฉบับล่าสุดที่ใช้กับเครื่องสำอางตอนนี้คือ ISO 17516: 2014 เรียกวิธีตรวจหาปริมาณเชื้อจุลินทรีย์ว่า "Microbiological Limits"
United States Pharmacopeia (USP)
มาตรฐาน USP จะไม่เจาะจงว่าเป็นเครื่องสำอาง แต่จะเรียกว่า ผลิตภัณฑ์ไม่ปราศจากเชื้อที่ใช้กับผิวหนัง เรียกวิธีตรวจหาปริมาณเชื้อว่า "Microbial Enumeration Tests"
Thai Herbal Pharmacopoeia (THP)
มาตรฐาน THP ใช้คําว่า ผลิตภัณฑ์ยาไม่ปราศจากเชื้อที่ใช้กับผิวหนัง ทั้งที่มีและไม่มีสมุนไพร และเรียกวิธีตรวจหาปริมาณเชื้อว่า "Microbial Limit Tests" โดยแบ่งขีดจำกัด 2 แบบ ผลิตภัณฑ์ยาไม่ปราศจากเชื้อที่ใช้กับผิวหนังเต็ม และ ผลิตภัณฑ์ยาไม่ปราศจากเชื้อที่ใช้กับผิวหนังเต็มที่มีสมุนไพร

ประกาศกระทรวงสาธารณสุข เรื่อง กำหนดลักษณะของเครื่องสำอางที่ห้ามผลิต นำเข้า หรือขาย พ.ศ.2559
1. ให้เครื่องสำอางที่มีคุณสมบัติทางจุลชีววิทยาตามที่กำหนดไว้ดังต่อไปนี้ เป็นเครื่องสำอางที่ห้ามผลิต นำเข้า หรือขาย
(1) เครื่องสำอางที่ตรวจพบเชื้อจุลินทรีย์ที่ก่อให้เกิดโรค ดังต่อไปนี้
ซูโดโมแนส แอรูจิโนซา (Pseudomonas aeruginosa)
สตาฟิโลค็อกคัส ออเรียส (Staphylococcus aureus)
แคนดิดา อัลบิแคนส์ (Candida albicans)
คลอสตริเดียม (Clostridium spp.) (เฉพาะเครื่องสำอางสมุนไพร)
(2) เครื่องสำอางที่ใช้บริเวณรอบดวงตา เครื่องสำอางที่สัมผัสเยื่อบุอ่อน และเครื่องสำอางสำหรับเด็กอายุต่ำกว่า 3 ปี ที่ตรวจพบจำนวนรวมของแบคทีเรีย ยีสต์ และรา ที่เจริญเติบโตโดยใช้อากาศ (Total aerobic plate count) มากกว่า 500 โคโลนีต่อกรัม หรือลูกบาศก์เซนติเมตร ขึ้นไป
(3) เครื่องสำอางอื่น นอกเหนือจากที่กำหนดใน (2) ที่ตรวจพบจำนวนรวมของแบคทีเรีย ยีสต์ และรา ที่เจริญเติบโตโดยใช้อากาศ (Total aerobic plate count) มากกว่า 1,000 โคโลนีต่อกรัม หรือลูกบาศก์เซนติเมตร ขึ้นไป
2. คุณสมบัติทางจุลชีววิทยาตามข้อ 1 ให้ทดสอบตามวิธีที่ระบุไว้ในมาตรฐาน International Organization for Standardization (ISO) หรือ United States Pharmacopeia (USP) ในเรื่องที่เกี่ยวข้อง ฉบับล่าสุด หรือวิธีอื่นที่เป็นมาตรฐานสากลเป็นที่ยอมรับ
มาตรฐานผลิตภัณฑ์อุตสาหกรรม ผลิตภัณฑ์ทาบำรุงผิว
กำหนดคุณลักษณะที่ต้องการทางจุลชีววิทยาไว้ดังนี้
1. จำนวนรวมของแบคทีเรีย ยีสต์และราที่เจริญโดยใช้อากาศ (aerobic plate count) ต้องไม่เกิน 1,000 โคโลนีต่อกรัมหรือโคโลนีต่อลูกบาศก์เซนติเมตร
2. ต้องไม่พบจุลินทรีย์ที่ก่อให้เกิดโรค ดังต่อไปนี้
(1) ซูโดโมแนส แอรูชิโนซา (Pseudomonas aeruginosa)
(2) สตาฟิโลค็อกคัส ออเรียส (Staphylococcus aureus)
(3) แคนดิดา อัลบิแคนส์ (Candida albicans)
(4) คลอสตริเคียม (Clostridium spp.) (เฉพาะเครื่องสำอางผสมสมุนไพร)

เครื่องสำอางเป็นผลิตภัณฑ์ที่สามารถพบเชื้อจุลินทรีย์ได้แต่ต้องอยู่ในขีดจำกัดและจำเป็นต้องใส่สารกันเสีย หากการปนเปื้อนจุลินทรีย์เกินขีดจำกัดและสารกันเสียไม่มีประสิทธิภาพ จุลินทรีย์ที่อยู่ในเนื้อผลิตภัณฑ์เครื่องสำอางจะเจริญเติบโตและเพิ่มจำนวนขึ้น ส่งผลต่อการเปลี่ยนแปลงลักษณะทางกายภาพและคุณสมบัติทางเคมีของผลิตภัณฑ์ เช่น กลิ่นและสีเปลี่ยนไป มีการตกตะกอนหรือแยกชั้น เป็นต้น
วิธีการทดสอบทางจุลชีววิทยา แบ่งออกเป็น 2 แบบ
1. การตรวจเชิงปริมาณ
การควบคุมคุณภาพของเครื่องสําอางเชิงปริมาณคือ การตรวจหาปริมาณเชื้อในเครื่องสําอางและการประเมินประสิทธิภาพของสารกันเสียในเครื่องสําอาง โดยใช้มาตรฐาน ISO
- ISO 21149: 2017 การตรวจและนับจํานวนแบคทีเรียที่เจริญในที่มีอากาศและในอุณหภูมิปานกลาง (aerobic mesophilic bacteria) ในเครื่องสําอาง ใช้วิธี Plate count method และ Membrane filtration method
- ISO 16212: 2017 การตรวจและนับจํานวนยีสต์และราในเครื่องสําอาง
การหาเชิงคุณภาพคือ บอกได้ว่าพบแบคทีเรียหรือไม่พบเท่านั้น มีแค่ในมาตรฐานของ ISO ไม่มีใน USP และ THP
- ISO 21149: 2017 ใช้วิธี Detection of bacteria by enrichment

เชื้อจุลินทรีย์บางชนิดทําให้คุณสมบัติทางเคมีและกายภาพของผลิตภัณฑ์เครื่องสําอางเปลี่ยนแปลงไป เช่น สีและกลิ่นเปลี่ยน แยกชั้นและตกตะกอน ค่า pH เปลี่ยน เป็นต้น และยังเป็นอันตรายต่อมนุษย์ จึงเป็นเชื้อที่ห้ามพบในเครื่องสำอาง มีดังนี้

ซูโดโมแนส แอรูชิโนซา (Pseudomonas aeruginosa)
- Pseudomonas aeruginosa หรือ P. aeruginosa
- ลักษณะ แบคทีเรียแกรมลบทรงแท่งสั้น (Gram-negative rod) โคโลนีเรียบ มีกลิ่นเฉพาะตัวคล้ายกลิ่นองุ่น
- แหล่งที่พบ สิ่งแวดล้อม เช่น ดิน และนํ้า ขยะ พืช สระว่ายน้ำ นอกจากนี้ยังพบในผิวหนังคนสุขภาพดี เป็นเชื้อประจำถิ่นในลำไส้คนและสามารถก่อโรคในคนได้
- บริเวณที่ติดเชื้อ ผิวหนัง ตา ทางเดินหายใจ และทางเดินปัสสาวะ
- ความสามารถ สร้างสีฟีนาซีน (phenazine) หรือไพโอไซยานิน (pyocyanin) ซึ่งเป็นสีเขียวแกมนํ้าเงิน ทนต่อสารชะล้าง (detergent) บางชนิด และสามารถสร้างไบโอฟิล์ม (biofilm) ได้ จึงทําลายยาก เกิดการติดเชื้ออย่างรุนแรงในคน

สตาฟิโลค็อกคัส ออเรียส (Staphylococcus aureus)
- Staphylococcus aureus หรือ S. aureus
ลักษณะ แบคทีเรียแกรมบวกรูปร่างกลม ส่วนใหญ่อยู่เป็นกลุ่ม (Gram-positive cocci) ลักษณะพวงองุ่น โคโลนีกลมเรียบสีเหลืองทอง - แหล่งที่พบ ผิวหนังคนสุขภาพดี เป็นเชื้อประจําถิ่นบนผิวหนังและโพรงจมูก (normal flora in human) จัดเป็นเชื้อก่อโรคฉวยโอกาส (opportunistic pathogen)
- บริเวณที่ติดเชื้อ ผิวหนัง
- ความสามารถ ก่อโรคในผิวหนังเฉพาะที่ เช่น ตากุ้งยิง ฝีบนผิวหนัง หรืออาจแพร่ไปผิวหนังบริเวณอื่น เช่น ทําให้เกิดเซลล์เนื้อเยื่ออักเสบ (cellulitis) หรือ เป็นโรคพุพอง (impetigo)

แคนดิดา อัลบิแคนส์ (Candida albicans)
- Candida albicans หรือ C. albicans
- ลักษณะ เป็นเชื้อที่สามารถเจริญได้ทั้งแบบยีสต์ (yeast) ซึ่งเป็นสิ่งมีชีวิตเซลล์เดียว โคโลนี กลม ๆ คล้าย แบคทีเรียแต่ขนาดใหญ่กว่า มักเกิดในสภาวะอากาศเย็น และเจริญได้แบบรา (mold) ซึ่งเป็นสิ่งมีชีวิตที่มีหลายเซลล์และมีการสร้างเส้นใย (hyphae) มักพบในสภาวะอากาศร้อน
- แหล่งที่พบ พบได้ตามสิ่งแวดล้อม เป็นเชื้อประจําถิ่นในผิวหนัง
- บริเวณที่ติดเชื้อ ทางเดินหายใจ ทางเดินอาหาร ทางเดินปัสสาวะในเพศหญิง เป็นเชื้อก่อโรคฉวยโอกาส (opportunistic pathogen) เมื่อมีภาวะภูมิคุ้มกันบกพร่อง
- ความสามารถ คงทนเมื่ออยู่ภายนอกร่างกายและสามารถสร้างไบโอฟิล์มได้ จึงกําจัดได้ยาก ในช่องคลอดจะมีเชื้อ Lactobacilli ซึ่งจะช่วยยับยั้งการเจริญเติบโตของ C. albicans ได้ หาก Lactobacilli ลดลง เชื้อ C. albicans จะเจริญและแพร่เชื้อทําให้เกิดโรคติดเชื้อราในช่องคลอด (vaginal candidiasis) การติดเชื้อทางผิวหนัง และฝ้าขาวในช่องปากได้

คลอสตริเดียม (Clostridium spp.)
- Clostridium species ได้แก่ C. perfringens, C. difficile, C. perfringens, C. novyi, C. septicum, C. tetani และ C. botulinum ตรวจเฉพาะในเครื่องสำอางที่ผสมสมุนไพร
- ลักษณะ แบคทีเรียแกรมบวกทรงแท่ง เจริญแบบไม่ใช้ออกซิเจน (anaerobe)
- แหล่งที่พบ ดิน น้ำ อากาศ พืช บางครั้งพบในลําไส้ของคนและสัตว์ และในทางเดินของอวัยวะสืบพันธุ์เพศหญิงที่มีสุขภาพดี
- ความสามารถ สร้างเอนโดสปอร์อยู่ภายในเซลล์ (endospore) ทําให้ทนต่อการทําลายด้วยความร้อนมาก ป้องกันการทําลายของคอมพลีเมนต์ (complement) ในระบบภูมิคุ้มกัน สร้าง exotoxin ทําให้เกิดโรคร้ายแรง และยังก่อให้เกิดโรคบาดทะยัก (tetanus) และเกิดพิษต่อระบบประสาทที่เรียกว่า botulism

เอสเชอริเชีย โคไล (Escherichia coli)
- Escherichia coli หรือ E. coli
- ลักษณะ แบคทีเรียแกรมลบทรงแท่งสั้น
- แหล่งที่พบ สิ่งแวดล้อมที่ชื้น เช่น อากาศ นํ้า ดิน เป็นเชื้อประจําถิ่นในลําไส้ของมนุษย์และสัตว์เลือดอุ่น ซึ่งอาจมักพบออกมากับอุจจาระ โดยปกติจะไม่ทำอันตรายหรือก่อโรคร้ายแรง
- บริเวณที่ติดเชื้อ ทางเดินปัสสาวะ ลำไส้ใหญ่ เลือด สมอง
- ความสามารถ หากเชื้อ E. coli ลุกล้ำเข้าสู่ระบบต่าง ๆ ของร่างกาย ก็จะทำให้เกิดโรคติดเชื้อรุนแรง เช่น โรคติดเชื้อระบบทางเดินปัสสาวะ โรคเยื่อหุ้มสมองอักเสบ โรคอุจจาระร่วง และการติดเชื้อในกระแสเลือด เป็นต้น

จากประกาศกระทรวงสาธารณสุข "วัตถุกันเสีย" หมายความว่า วัตถุที่ใช้ในการยับยั้งการเจริญเติบโตของเชื้อจุลินทรีย์ในเครื่องสำอาง โดยวัตถุกันเสียหรือสารกันเสียที่อาจใช้เป็นส่วนผสมในการผลิตเครื่องสำอางต้องเป็นไปตามที่กำหนด ซึ่งวัตถุกันเสียที่พบเห็นได้บ่อย เช่น
Phenoxyethanol ยับยั้งเชื้อแบคทีเรียได้ดี แต่ยับยั้งยีสต์และราได้ไม่ค่อยดี เหมาะสำหรับเครื่องสำอางที่ใช้กับผิวและผม
Parabens เหมาะสำหรับเครื่องสำอางที่เชื้อจุลินทรีย์เข้าถึงได้ง่าย เช่น สบู่ก้อน ตัวที่อนุญาตให้ใช้ เช่น Methylparaben, Ethylparaben, Butylparaben และ Propylparaben เป็นต้น ส่วน Phenylparaben, Benzylparaben, Pentylparaben, Isopropylparaben และ Isobutylparaben ห้ามใช้ในเครื่องสำอาง
Sodium Benzoate และ Potassium Sorbate เหมาะกับการใช้เป็นสารกันเสียในผลิตภัณฑ์ที่ต้องสัมผัสกับปาก หรือเข้าปาก
Chlorphenesin ยับยั้งเชื้อจุลินทรีย์ได้ดีทั้งแบคทีเรีย ยีสต์ และรา เหมาะสำหรับเครื่องสำอางที่ใช้กับผิวและผม
Polyhexamethylene biguanide hydrochloride (PHMB) เป็นสารกันเสียที่อ่อนโยน ยับยั้งเชื้อโรคได้กว้างรวมไปถึงไวรัส ลดกลิ่นที่เกิดจากแบคทีเรีย เหมาะสำหรับเครื่องสำอางบริเวณรอบดวงตา
Iodopropynyl Butyl Carbamate ยับยั้งเชื้อจุลินทรีย์ได้อย่างครอบคลุม เหมาะสำหรับเครื่องสำอางล้างออก
DMDM Hydantoin ยับยั้งเชื้อจุลินทรีย์ได้อย่างครอบคลุม ออกฤทธิ์ที่ pH 3-9 เหมาะสำหรับเครื่องสำอางที่ใช้กับผิว มีข้อเสียคือปลดปล่อย formaldehyde ออกมา
o-Cymen-5-ol หรือ Isopropyl methylphenol สารที่พบได้ในต้น Thyme มีฤทธิ์ฆ่าเชื้อโรค มีความปลอดภัยสูง ใช้ได้กับทุกผลิตภัณฑ์เครื่องสำอาง

เครื่องสำอางเป็นผลิตภัณฑ์ที่ไม่ปราศจากเชื้อ การปนเปื้อนเชื้อจุลินทรีย์จึงเป็นหนึ่งในปัญหาที่สําคัญในอุตสาหกรรมเครื่องสําอาง ดังนั้นจึงต้องมีการทดสอบทางชีวภาพ เพื่อประเมินความคงตัวและความเสี่ยงของเครื่องสําอางทางจุลชีววิทยา เป็นหนึ่งในการประกันคุณภาพผลิตภัณฑ์เครื่องสําอาง ให้ผลิตภัณฑ์เครื่องสําอางมีคุณภาพและปลอดภัยต่อผู้บริโภค
รวบรวมเนื้อหาจากแหล่งที่มา
ประกาศกระทรวงสาธารณสุข เรื่อง กำหนดลักษณะของเครื่องสำอางที่ห้ามผลิต นำเข้า หรือขาย พ.ศ.2559
ประกาศกระทรวงสาธารณสุข เรื่อง กำหนดวัตถุกันเสียที่อาจใช้เป็นส่วนผสมในการผลิตเครื่องสำอาง พ.ศ. 2560
มาตรฐานผลิตภัณฑ์อุตสาหกรรม ผลิตภัณฑ์ทาบำรุงผิว


